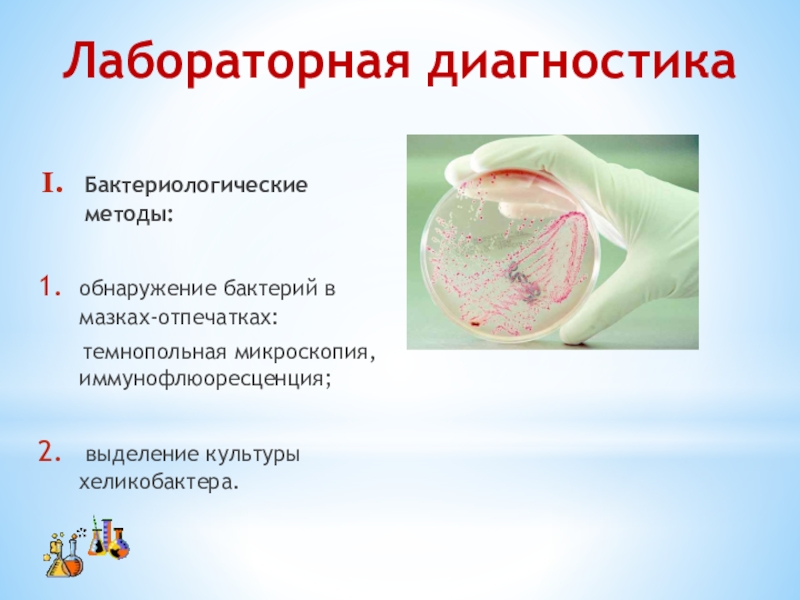
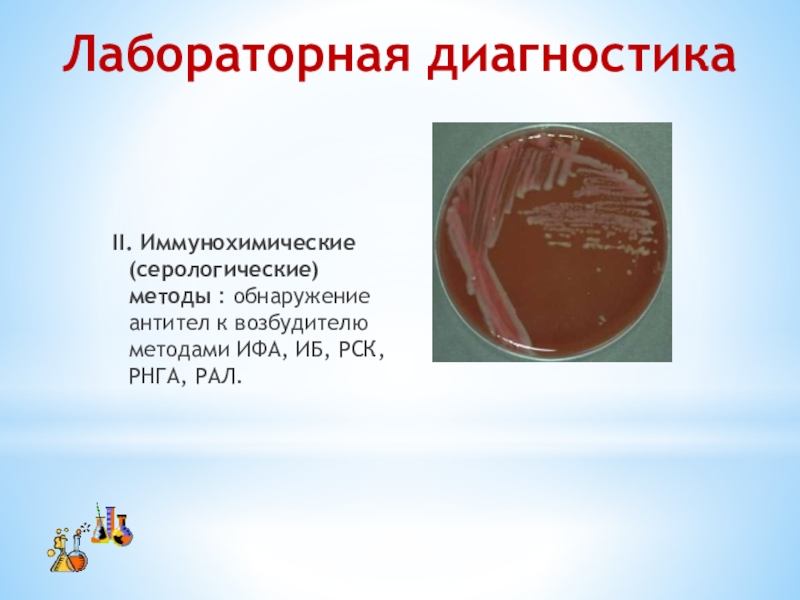

Красноярск,
2020
Руководитель: Л.А.Роппельт
Разработал:
студент 4 курса группы 43 специальности 34.02.01 Сестринское дело очно-заочной формы обучения А.В. Пятницкая
СОВРЕМЕННЫЕ ВИДЫ ДИАГНОСТИКИ
ХЕЛИКОБАКТЕР ПИЛОРИ.
Приложение 2